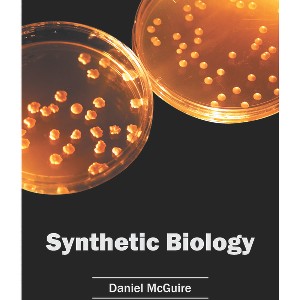

Sponsored
Synthetic Biology - by Daniel McGuire (Hardcover)
$109.99Save $47.00 (30% off)
In Stock
Eligible for registries and wish lists
Sponsored
About this item
Highlights
- Synthetic biology is a rapidly evolving discipline which integrates concepts of engineering with that of biology.
- Author(s): Daniel McGuire
- 278 Pages
- Science, Life Sciences
Description
About the Book
Synthetic biology is a rapidly evolving discipline which integrates concepts of engineering with that of biology. It is a field which has applications in a number of innovative fields, such as diagnostics, designing innovative biological systems to fabricate materials, etc. This book includes some of the vital researches being conducted across the world, on various topics related to synthetic biology, such as cell design, synthetic DNA, designed proteins, biosensors, etc. As this field is emerging at a rapid pace, the contents of the text will help the readers understand the modern concepts and applications of the subject. It is highly recommended for students and academicians pursuing synthetic biology, biotechnology and allied fields of study.
Book Synopsis
Synthetic biology is a rapidly evolving discipline which integrates concepts of engineering with that of biology. It is a field which has applications in a number of innovative fields, such as diagnostics, designing innovative biological systems to fabricate materials, etc. This book includes some of the vital researches being conducted across the world, on various topics related to synthetic biology, such as cell design, synthetic DNA, designed proteins, biosensors, etc. As this field is emerging at a rapid pace, the contents of the text will help the readers understand the modern concepts and applications of the subject. It is highly recommended for students and academicians pursuing synthetic biology, biotechnology and allied fields of study.
Dimensions (Overall): 11.0 Inches (H) x 8.5 Inches (W) x .69 Inches (D)
Weight: 2.07 Pounds
Suggested Age: 22 Years and Up
Number of Pages: 278
Genre: Science
Sub-Genre: Life Sciences
Publisher: Syrawood Publishing House
Theme: Biology
Format: Hardcover
Author: Daniel McGuire
Language: English
Street Date: May 30, 2016
TCIN: 1005848111
UPC: 9781682863374
Item Number (DPCI): 247-02-6918
Origin: Made in the USA or Imported
If the item details aren’t accurate or complete, we want to know about it.
Shipping details
Estimated ship dimensions: 0.69 inches length x 8.5 inches width x 11 inches height
Estimated ship weight: 2.07 pounds
We regret that this item cannot be shipped to PO Boxes.
This item cannot be shipped to the following locations: American Samoa (see also separate entry under AS), Guam (see also separate entry under GU), Northern Mariana Islands, Puerto Rico (see also separate entry under PR), United States Minor Outlying Islands, Virgin Islands, U.S., APO/FPO
Return details
This item can be returned to any Target store or Target.com.
This item must be returned within 90 days of the date it was purchased in store, shipped, delivered by a Shipt shopper, or made ready for pickup.
See the return policy for complete information.
Trending Non-Fiction



Highly rated
$18.28
was $19.58 New lower price
Save $5 when you spend $25 on select books
4.8 out of 5 stars with 23 ratings














